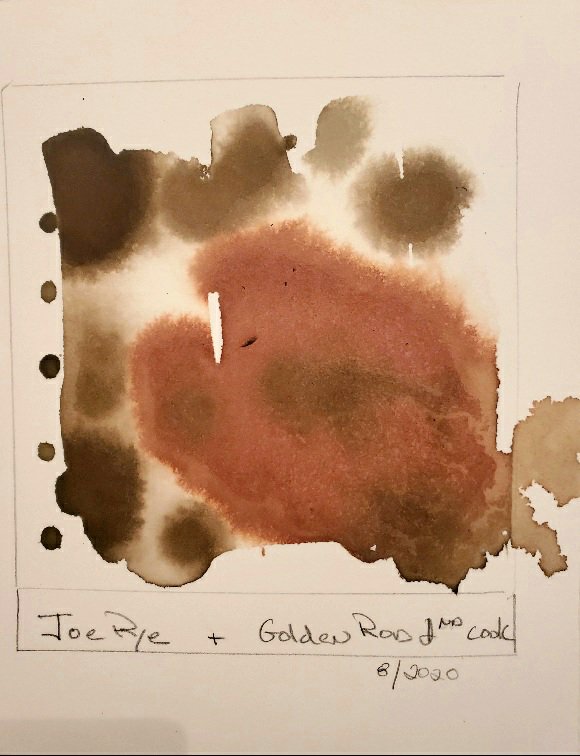

A Socially Distant Art Installation

A few weeks ago I was privileged to participate in an exhibition with my good friend and artist Hannie Eisma Varosy. We were planning our biannual art exhibition which was going to be a continuation of the 2018 one but life as we all know it took a more solitary turn in March and we both found ourselves creating very different art.

Inks and notes 
Inks Teas and artwork 
Eco prints and artwork 
Goldenrod, cherry, joe pye, and daylily 
Installation
Exhibition Statement
In January I started making eco ink prints with natural plant materials that I found i.e. leaves and grasses; I had the idea of using the prints as a starting point for much larger collages. I continued the printing through mid-March when in the midst of Covid 19 I ran out of black ink. With all the stores closed and the only art supply store online not able to deliver for 3 to 4 weeks I got intrested in finding out how to make it.

The process is fairly easy: 1. Find your ingredient 2. Prepare it. 3. Intensify the color 4. Filter the color 5. Make it permanent 5. Bottle it 6. Test it.

” natural ink is a landscape condensed into a little bottle”.
Jason Logan
During one of our conversations about the art show Hannie and I concluded that my art this year became about the process rather than the outcome and it was with that in mind that we put together the installation.
Needless to say I am now completely enchanted by natural ink. It has become a very in-depth journey about the process, the chemistry, and the way that color can be extricated from simple found matter and placed into a very tiny bottle to make marks. It continues to be an enlightening and exciting process as I go through the seasons.

Back story: In August 2018 my sister Carol, who is an herbalist, asked if I would like her to make me some black walnut ink from the tree in my mother’s yard. I remember there was a bit of a story in the making of the ink, something about bugs and a not so great smell. She made a big bottle of it and gave it to me that October. When I ran out of black ink, Carol was the first person I called. She is a wealth of information and recommended that I read Make Ink: A Forager’s Guide to Natural Inkmaking by Jason Logan and also anything I could about natural dyes since the two are very closely related.
If you would like to know more about ink making and what I am up to, take look at my other posts on this blog and sign up to get notifications.. http://www.leahmccloskeyart.com